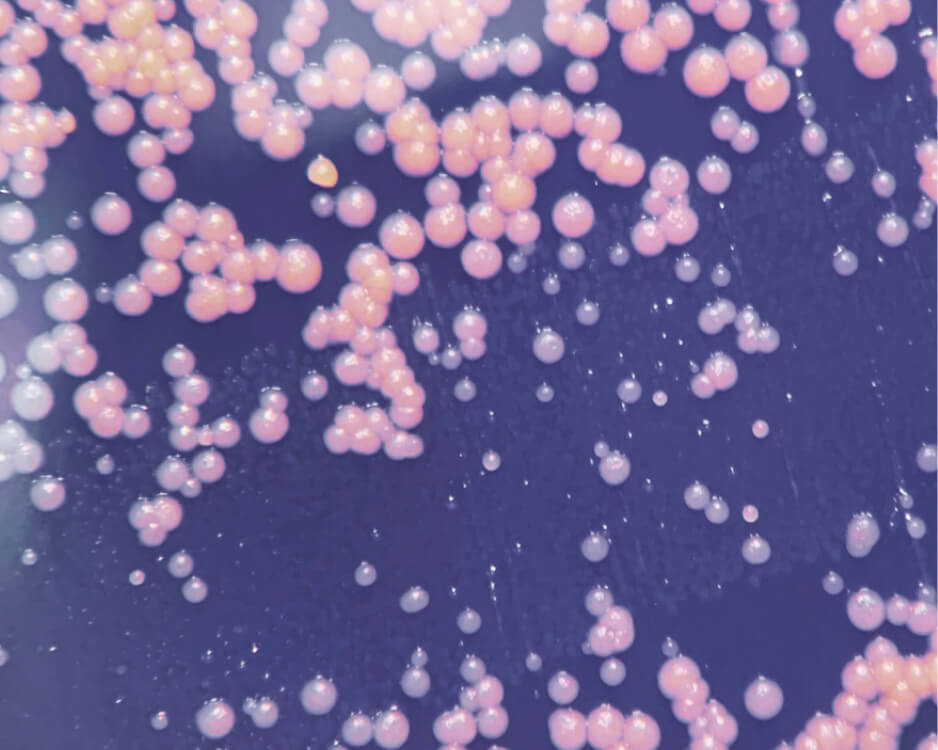

EMMA LEWISHAM
The skincare line from Auckland, New Zealand, was founded in 2019 by Emma Lewisham – with the approach that unites luxurious, science-led natural skincare with pioneering progress in sustainability. Developed by leading physiologists and biochemists, the range focuses on skin physiology rather than individual ingredients, with its efficacy confirmed by independent biomedical testing worldwide. Each product is fundamentally formulated using a proprietary methodology. Emma Lewisham is a certified B Corp and was the world’s first climate positive certified and 100% circular designed (refillable) beauty brand—reducing carbon emissions by up to 74%. Their sustainability practices have garnered endorsement from globally renowned environmentalist, Dr. Jane Goodall.